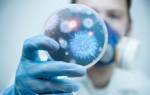

Острый бронхит – одно из наиболее частых заболеваний дыхательных путей, достигающих среди детской аудитории более 100 случаев на 1000 детей ежегодно. Среди детей раннего возраста, госпитализированных в респираторные отделения с острым бронхитом, численность составляет больше половины всех больных. Лечение острого бронхита у детей необходимо осуществлять своевременно и под наблюдением специалистов.
Неадекватные методы лечения ребенка приводят к рецидивирующей и хронической форме бронхитов, а также к бронхиальной астме, симптомы и последствия таких заболеваний нередко приводят к летальному исходу.
Возбудители заболевания
Острый бронхит у ребенка возникает под влиянием респираторных вирусных и бактериальных инфекций. К вирусным возбудителям относятся:
- вирусы гриппа/парагриппа;
- рино- и аденовирусы;
- крона и коксаки-вирусы.
Вышеперечисленные вирусы в равном процентном соотношении вызывают острый бронхит, как у детей, таки у взрослых. Вирусные инфекции верхних дыхательных путей чаще встречаются у детей от 6 месяцев до 3 лет.

- хламидии;
- микоплазмы;
- стрептококк;
- стафилококк.
Вышеперечисленные бактерии способны длительное время находится в организме ребенка без выраженной симптоматики. Бактерии активируются при послаблении иммунной системы, парализуя механизмы защиты слизистых оболочек органов дыхания, воздействуют на бронхи, раздражая и вызывая устойчивые спазмы гладкой мускулатуры бронхов, что приводит к приступам сухого кашля. Бактерии еще больше угнетают иммунную систему, что приводит к ослаблению сопротивляемости организма по отношению к другим заболеваниям.
При поражении бронхов хламидийной инфекцией у детей наблюдается затяжное течение заболевания. При инфицировании стрептококком и стафилококком наблюдается бактериальные очагов в ЛОР-органах. У таких больных определяются признаки купирования слизи в бронхах, а также признаки тяжелой дыхательной недостаточности. Микоплазамы вызывают характерную одышку и гиперсекрецию слизи в бронхах.

- синусит;
- тонзиллит;
- гайморит;
- аденоид.
Риновирусные инфекции наиболее активны в осенний период, аденоидные вирусы активируются в весенний период,вирусы гриппа и парагриппа в зимний период. Это объясняет, почему у ребенка острый бронхит развивается неоднократно в течение одного года.
Данные многочисленных исследований указывают, что если клиническая картина острого бронхита развивается у ребенка медленно в течение 2-5 дней, можно предположить, что бронхит развился на фоне вирусных инфекций. Если характерные симптомы острого бронхита разворачиваются более чем 7-10 дней, скорее всего речь идет о бактериальной этиологии заболевания.
Врачи подчеркивают, что лечение острого бронхита у детей требует индивидуального подхода и тщательного наблюдения. Основное внимание уделяется облегчению симптомов и поддержанию дыхательной функции. Важно обеспечить ребенку достаточное количество жидкости, чтобы предотвратить обезвоживание и разжижить мокроту. Специалисты рекомендуют использовать ингаляции с физиологическим раствором, что способствует улучшению отхождения мокроты.
При наличии высокой температуры могут быть назначены жаропонижающие средства. Врачам также важно следить за тем, чтобы не допустить развития осложнений, таких как пневмония. В некоторых случаях может потребоваться применение бронхолитиков или противовирусных препаратов, особенно если бронхит вызван вирусной инфекцией. В целом, ключевым аспектом является создание комфортных условий для выздоровления и регулярное наблюдение за состоянием ребенка.

Клиническая картина острого бронхита у детей
Согласно современной классификации острый бронхит – выраженный воспалительный процесс, поражающий слизистую оболочку бронхов, без патологического влияния на легочную ткань. Воспалительный процесс развивается преимущественно на фоне заражения вирусной и бактериальной инфекцией. Выделяют основные симптомы острого бронхита в соответствии с тремя фазами заболевания.
Начальная фаза или инкубационный период
На данном этапе заболевания иммунная система ребенка пытается справиться с инфекцией в дыхательных путях. Основные симптомы:
лихорадка;
- боль в мышцах;
- головная боль;
- боль в груди;
- слабость;
- сухой кашель.
Начальная фаза длиться от 2 до 5 дней. Заболевание на протяжении первых трех дней может протекать со скудной симптоматикой. Более того, очень сложно дифференцировать респираторную вирусную инфекцию и острый бронхит.
Если кашель и боль в груди сохраняется более 5-6 дней, то такие симптомы указывают на развитие острого бронхита.
Так, на ранней стадии развития заболевания, у детей наблюдается кашель, который на 5-6 день из эпизодического сухого кашля переходит в надрывно-мучительный кашель в связи с отсутствием обструкции.
Такой кашель может наблюдаться не только днем, но и во время сна, что очень сильно изматывает ребенка.Кашель может сопровождаться не только болью в груди, но и хрипами, которые каждый раз усиливаются во время кашля.
Лечение острого бронхита у детей вызывает много обсуждений среди родителей и врачей. Многие отмечают, что важным аспектом является своевременная диагностика. Врачи рекомендуют не заниматься самолечением и обращаться за помощью при первых симптомах, таких как кашель и затрудненное дыхание. Родители делятся опытом, что использование ингаляторов и увлажнителей воздуха значительно облегчает состояние ребенка. Также часто упоминается о важности поддержания водного баланса и применения теплых напитков. Некоторые специалисты подчеркивают, что антибиотики не всегда необходимы, так как большинство случаев бронхита вызваны вирусами. Важно следить за общим состоянием ребенка и при ухудшении обращаться к врачу. В целом, комплексный подход к лечению, включающий отдых, правильное питание и медикаментозную терапию, помогает быстрее справиться с заболеванием.
Прогрессирующая фаза
Длится от 7 до 15 дней. Кашель отличается частотой проявлений и устойчивостью. Вследствие воспалительного процесса в бронхах,дыхательные пути претерпевают патологические изменения, становятся гиперактивными, в результате чего наблюдаются следующие симптомы:
затяжной кашель;
- дыхательная недостаточность;
- «свистящее» дыхание;
- хрипы;
- одышка;
- насморк;
- мокрота.
Такие симптомы как температура и мокрота проявляются достаточно редко. Температура чаще находится на субфебрильном уровне, может достигнуть высоких значений, если острый бронхит протекает на фоне рино- и аденовируса. В конце прогрессирующей фазы заболевания может проявиться мокрота. Для острого бронхита характерно отделение только прозрачной мокроты.
Критическая фаза
Данный этап характеризуется как запущенная форма острого бронхита. Нередко данная фаза наступает вследствие неадекватной и несвоевременной терапии, что приводит к таким осложнениям как бронхиолит и пневмония.

- навязчивый кашель;
- высокая температура;
- гнойный экссудат.
Высокая температура проявляется при развитии бронхиолита и пневмонии, гнойная мокрота только при развитии пневмонии. Если не лечить острый бронхит до полного его исчезновения, то заболевание может перейти в хроническую форму бронхита. При своевременном лечении, клиническая картина острого бронхита длится не более 2-3 недель.
Врожденные факторы, способствующие развитию острого бронхита
Многие родители задаются вопросом, почему у детей острый бронхит развивается чаще, чем у взрослых. В педиатрии и пульмонологии выделяют 3 фактора:
-
Несовершенная иммунная система. У детей иммунная система совершенствуется и усложняется с рождения до подросткового возраста. В связи с тем, что процесс развития иммунной системы длится несколько лет, соответственно, защитные функции организма снижены, что делает ребенка уязвимым и чувствительным к инфекционным, грибковым и вирусным заболеваниям.
Педиатры рекомендуют родителям в качестве иммуннокорректирующей терапии организовать сбалансированное питание, физические нагрузки, прогулки на свежем воздухе. Если возраст и состояние здоровья ребенка позволяет, то можно периодически осуществлять процедуры закаливания.
-
Анатомическое и физиологическое недоразвитие верхних дыхательных путей. Развитие органов дыхание у детей заканчивается в возрасте 7-8 лет, а рост органов дыхания продолжается параллельно с организмом примерно до 25 лет.
У детей поражение бронхов вирусными и бактериальными инфекциями происходит преимущественно в результате несформированности слизистой оболочки бронхов, которая характеризуется в период раннего возраста как рыхлая и сухая. Несмотря на то, что бронхиальное дерево у детей считается сформированным с 6 месяцев, то дыхательная мускулатура остается недоразвитой еще до 2-3 лет.
В результате при заболевании острым бронхитом в бронхиальном древе скапливается плотная жидкость и закупоривает бронхиальные просветы. Несовершенная дыхательная мускулатура не дает ребенку откашляться и вывести мокроту из дыхательных путей, такие процессы приводят к тяжелому течению заболевания с рецидивирующими проявлениями и осложнениями.
-
Патология мукоцилиарного клиренса. Мукоцилиарная система отвечает за транспортировку бронхиального секрета, которая происходит посредством двигательной деятельности ресничек, расположенных на слизистых оболочках дыхательных путей.
Мукоцилиарная транспортная функция обеспечивает санацию дыхательных путей, очищает и защищает организм от влияния патогенных вирусов. Патология мукоцилиарного клиренса в результате мучительного кашля вызывает высокое давление в брюшной полости, что приводит к утолщению стенок брюшной полости.
Вышеперечисленные факторы воздействуют на респираторные пути, а также являются причинами многих патологических изменений в организме.
Методы диагностики
Острый бронхит имеет общие симптомы с простудными и более сложными заболеваниями дыхательных путей. В связи с этим специалист должен осуществить несколько диагностических мероприятий для постановки точного диагноза.

Полученные результаты биохимического анализа позволят педиатру определить наличие или отсутствие воспалительного процесса в бронхах, а также выявить какими патогенными бактериями или вирусами были поражены дыхательные пути. Результаты иммунологического анализа, соответственно, о состоянии иммунной системы.
Исследование бронхов посредством рентгеноскопии проводится при длительном течении заболевания, с целью исключить или подтвердить развитие таких осложнений как бронхиолит и пневмония.
Для определения тяжести нарушения дыхания проводится спирометрия. Этот метод позволяет специалисту не только назначить терапию, но и контролировать эффективность медикаментозного лечения.
Метод аускультации проводится с целью выявить наличие или отсутствие дыхательной недостаточности, а также перекуторный звук в бронхах. Методом аускультации довольно сложно собрать информацию для выявления у детей таких заболеваний как острый бронхит и бронхопневмония, поскольку симптоматика этих заболеваний перекликается между собой, в связи с этим трудно дифференцируются и требуют другие методы диагностики.
Терапия и профилактика недуга
В педиатрии медикаментозное лечение представляет собой комплекс противовоспалительных, бронходилятаторных, кортикостероидных, муколитических и иммунотропных препаратов. Длительность противовоспалительной терапии при остром бронхите составляет 7-8 дней.

А также лечить острый бронхит антибиотиками рекомендуется только в том случае, если в течение 10 дней у ребенка не наступило клиническое улучшение и есть риск развития пневмонии. Назначаются антибиотики и при наличии хронического аденоидита, синусита и тонзиллита.
Лечить детей рекомендуется муколитическими препаратами при кашле. Такие препараты активируют дренажную и транспортную функцию бронхов.
Важно отметить, что препараты должны применяться только при высоких показателях плотности и вязкости мокроты.
В противном случае, под влиянием препаратов, мокрота станет излишне жидкой, в результате чего может развиться бронхорея. К мукоактивным препаратам относятся – Бромгексин, Амброксол и их производные.

- ингаляции с изотоническими растворами соли, соды;
- дренажный массаж.
Данные процедуры не могут быть основным лечением острого бронхита. Применяются в качестве дополнения к медикаментозному лечению.
Лечить острый бронхит посредством горчичников, мазей и бальзамов для растирания следуют крайне осторожно, так как повышается риск проявлений аллергических реакций, а также может вызвать раздражающее действие в бронхах и спровоцировать приступ кашля с удушьем.
К народным методам лечения острого бронхита относятся:
- Фитопрепараты для разжижения мокроты – корень солодки, корень алтея.
- Травы с отхаркивающим эффектом – мать-и мачеха, подорожник,алтей, солодка, душица.
- Иммунотропные препараты растительного происхождения – боярышник, женьшень, лимонник, алоэ.
Растительные травы помогают повысить функциональную деятельность бронхов, от активности которой зависит продвижение и транспортировка мокроты по дыхательным путям. Снижают бронхиальный спазм, а также раздражение слизистых оболочек. В результате отхождение мокроты протекает легко, наблюдаются эпизодические приступы кашля.

Профилактика острого бронхита обусловлена соблюдением санитарно-гигиенических норм. Рекомендуется избегать скученности людей в осенние и зимние периоды, это позволит предупредить вирусные и бактериальное инфицирование. Детям необходимы ежедневные прогулки на свежем воздухе, а также сбалансированное питание. Для дополнительного укрепления иммунитета рекомендуются спортивные нагрузки и плавание.
Острый бронхит в раннем возрасте носит чаще вторичный характер и в большинстве случаев развивается в результате врожденных патологий дыхательных путей. Лечить заболевание следует только под наблюдение педиатра-пульмонолога.
https://youtube.com/watch?v=XWQCf3EKx1k
Вопрос-ответ
Каковы основные симптомы острого бронхита у детей?
Основные симптомы острого бронхита у детей включают кашель (часто с выделением мокроты), одышку, хрипоту, повышенную температуру, а также общее недомогание. Кашель может быть сухим в начале заболевания, но со временем становится влажным.
Какие методы лечения острого бронхита рекомендуются для детей?
Лечение острого бронхита у детей обычно включает обильное питье, использование отхаркивающих средств, ингаляции и, в некоторых случаях, противовирусные препараты. Важно также обеспечить ребенку покой и комфорт, а при необходимости — обратиться к врачу для назначения антибиотиков, если есть подозрение на бактериальную инфекцию.
Когда следует обратиться к врачу при остром бронхите у ребенка?
Обратиться к врачу следует, если у ребенка наблюдаются затрудненное дыхание, высокая температура, которая не снижается, сильный кашель, продолжающийся более 2-3 недель, или если появляются признаки обезвоживания. Также стоит обратиться за медицинской помощью, если состояние ребенка ухудшается.
Советы
СОВЕТ №1
Обязательно проконсультируйтесь с педиатром при первых признаках острого бронхита. Симптомы, такие как кашель, затрудненное дыхание или высокая температура, требуют профессиональной оценки и назначения правильного лечения.
СОВЕТ №2
Создайте комфортные условия для ребенка: поддерживайте оптимальную влажность в комнате и избегайте воздействия холодного воздуха. Увлажнители воздуха могут помочь облегчить дыхание и снизить раздражение дыхательных путей.
СОВЕТ №3
Следите за режимом питья. Обильное питье помогает разжижать мокроту и облегчает ее выведение. Предлагайте ребенку теплые напитки, такие как травяные чаи или компоты, чтобы поддерживать уровень гидратации.
СОВЕТ №4
Не забывайте о важности отдыха. Дайте ребенку достаточно времени для восстановления, избегайте физических нагрузок и обеспечьте спокойную обстановку для сна и отдыха.
лихорадка;
лихорадка; затяжной кашель;
затяжной кашель;
 Несовершенная иммунная система. У детей иммунная система совершенствуется и усложняется с рождения до подросткового возраста. В связи с тем, что процесс развития иммунной системы длится несколько лет, соответственно, защитные функции организма снижены, что делает ребенка уязвимым и чувствительным к инфекционным, грибковым и вирусным заболеваниям.
Несовершенная иммунная система. У детей иммунная система совершенствуется и усложняется с рождения до подросткового возраста. В связи с тем, что процесс развития иммунной системы длится несколько лет, соответственно, защитные функции организма снижены, что делает ребенка уязвимым и чувствительным к инфекционным, грибковым и вирусным заболеваниям. Анатомическое и физиологическое недоразвитие верхних дыхательных путей. Развитие органов дыхание у детей заканчивается в возрасте 7-8 лет, а рост органов дыхания продолжается параллельно с организмом примерно до 25 лет.
Анатомическое и физиологическое недоразвитие верхних дыхательных путей. Развитие органов дыхание у детей заканчивается в возрасте 7-8 лет, а рост органов дыхания продолжается параллельно с организмом примерно до 25 лет. Патология мукоцилиарного клиренса. Мукоцилиарная система отвечает за транспортировку бронхиального секрета, которая происходит посредством двигательной деятельности ресничек, расположенных на слизистых оболочках дыхательных путей.
Патология мукоцилиарного клиренса. Мукоцилиарная система отвечает за транспортировку бронхиального секрета, которая происходит посредством двигательной деятельности ресничек, расположенных на слизистых оболочках дыхательных путей.








